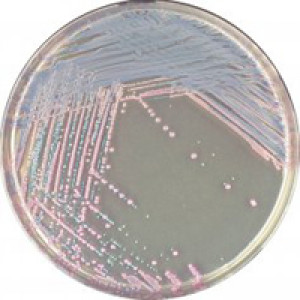

Intended Use:
CHROMagar™ Staph aureus is a selective chromogenic culture medium intended for use in the qualitative direct detection, differentiation and presumptive identification of Staphylococcus aureus to aid in the diagnosis of S. aureus colonization. The test is performed with swabs from teguments, wounds or soft tissue specimens. Results can be interpreted after 18-24 h of aerobic incubation at 35-37 °C.
The medium can also be used as an early warning indicator for diagnostic tests of infections to signal the possible presence of S. aureus. This use does not replace the institution’s protocols.
Concomitant cultures are necessary to recover organisms for further microbiological testing or epidemiological typing. A lack of growth or the absence of colonies on CHROMagar™ Staph aureus does not preclude the presence of S. aureus. CHROMagar™ Staph aureus is not intended to diagnose infection nor to guide nor monitor treatment for infections.
CHROMagar™ Staph aureus can also be used in the detection of S. aureus in the analyses of food products for human consumption, animal feed and in environmental samples.